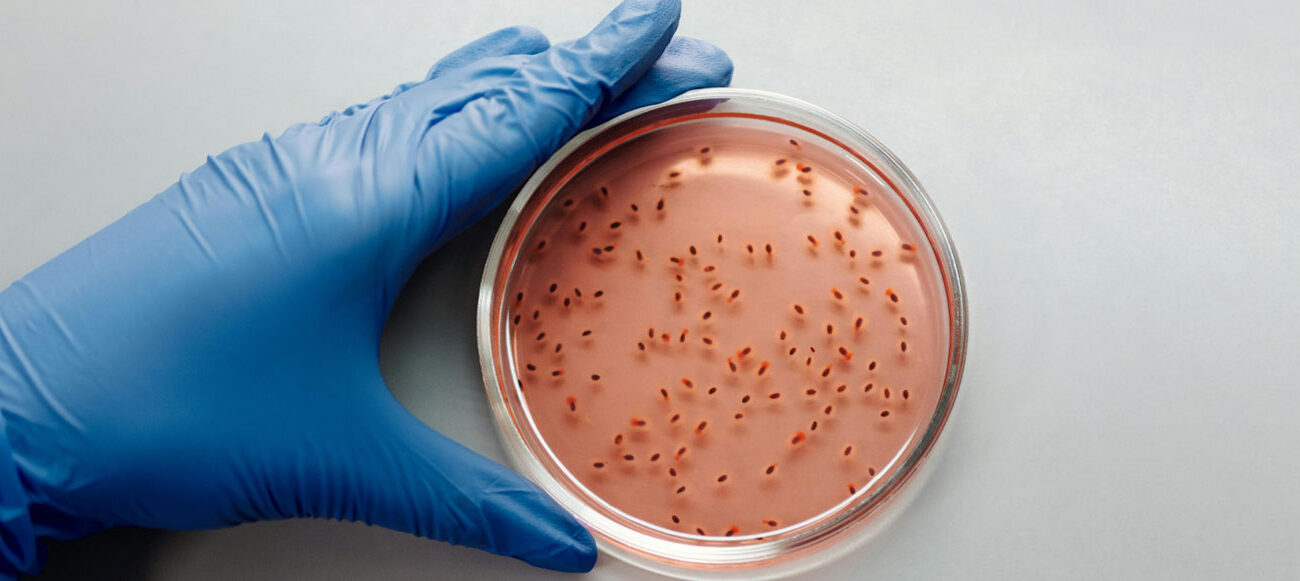

Çevrede Etkin Mikroorganizmalar (EM) kullanımı, su kirliliği, toprak verimliliği ve sanayi atıklarının yönetimi gibi çevresel sorunlarla mücadelede önemli bir çözüm sunmaktadır. EM teknolojisi, doğal mikroorganizmaların biyolojik gücünden yararlanarak kirleticileri parçalar, su kaynaklarını temizler ve toprak sağlığını korur. Özellikle sanayileşme ve kentleşme ile artan çevre kirliliği göz önüne alındığında, EM kullanımı, sürdürülebilir bir çevre yönetimi için etkili ve doğa dostu bir yaklaşımdır. Bu teknoloji, kimyasal gübreler ve pestisitler yerine biyolojik yollarla doğayı koruyarak, ekosistem dengesini sağlamaya yardımcı olur.
ETKİN MİKROORGANİZMALAR (EM) TEKNOLOJİSİ
Günümüzde çevre sorunları, doğal dengeyi ve sağlığı tehdit eden en büyük tehlikelerden biridir. Artan dünya nüfusu, sanayileşme ve gelişen yaşam standartları, bu sorunların boyutlarını büyütmektedir. Su kaynaklarındaki kirlenme, suyun yalnızca temin edilmesinin yeterli olmadığını, kalitesinin de izlenmesi gerektiğini göstermektedir. Türkiye’de hızla artan nüfus ve sanayileşme, su kaynakları üzerindeki baskıyı arttırmakta ve bu durum gelecekte daha da kritik hale gelecektir.
2025’te nüfusun 84 milyon olacağı tahmin ediliyor ve kişi başına düşen kullanılabilir su miktarı 1.300 m³’e düşecek. Bu nedenle, su kaynaklarının akılcı bir şekilde korunması ve yönetilmesi gerekmektedir. Su kirliliğine neden olan başlıca faktörler; sanayileşme, kentleşme, zirai ilaçlar ve kimyasal gübrelerdir. Sanayi atıkları su kirliliği ve toprak tahribatına yol açmakta, zirai ilaçlar ise su kaynaklarını pestisitlerle kirletmektedir. Aşırı kimyasal gübre kullanımı ise toprağın verimliliğini azaltmakta ve çevresel olumsuzluklara yol açmaktadır.

EKOLOJİ
Çevrenin belli başlı iki bileşkesi vardır:
![]() Canlılar
Canlılar
![]() Cansızlar
Cansızlar
Ekoloji, bu iki bileşke arasındaki karmaşık ilişkileri, karşılıklı etkileşimleri ve doğal dengeleri inceler. Bu nedenle kirlilik kontrolünde bir ekolojik sistemler (ekosistem) yaklaşımı gereklidir.
Canlı bileşke üç ana gruptan oluşur:
![]() Ana üreticiler (bitkiler, vejetasyon, algler)
Ana üreticiler (bitkiler, vejetasyon, algler)
![]() Tüketiciler (kurtçuklar, solucanlar, hayvanlar, insanlar)
Tüketiciler (kurtçuklar, solucanlar, hayvanlar, insanlar)
![]() Çürütücüler (mikroorganizmalar, örneğin bakteriler)
Çürütücüler (mikroorganizmalar, örneğin bakteriler)
Mikroorganizmaların bir kısmı aerobiktir ve oksijene bağımlıdırlar; bazıları sadece oksijensiz ortamlarda yaşarlar ve anaerobik olarak sınıflandırılırlar. Ayrıca hem oksijenli, hem de oksijensiz ortamda yaşayan fakültatif mikroorganizmalar da vardır. Cansız bileşkeler kapsamında ise su, gazlar, mineraller ve kimyasal maddeler sayılabilir.
Fotosentez, ana üreticiler için hayatın devamı anlamına gelen organik bileşikleri sağladığından tabiattaki en önemli proseslerden birisidir. Fotosentez, aynı zamanda tüm tüketiciler ve çürütücüler için de gerekli besinlerin dolaylı kaynağıdır. Organik madde mikroorganizmalar tarafından biyokimyasal olarak ayrıştırılır. Aerobik ortamda bu çürüme işleminin gerçekleşmesi için fotosentezle üretilen miktar kadar oksijen tüketilir ve aynı besinler inorganik olarak geri kazanılır. Çürüme işlemi anaerobik ortamda da gerçekleşir. Fakat nihai ürünler farklıdır ve bu ürünler de ortam tekrar aerobik olduğu takdirde oksitlenebilirler. Üreticilerin, tüketicilerin ve çürütücülerin beraberce bulunduğu bu tip ortamlar için göller, nehirler, toprak, koylar ve körfezler örnek olarak verilebilir. Eğer tüm dünyada üretilen organik maddeler aerobik bozunmaya uğrasaydı net oksijen üretimi sıfır olacaktı.
Fakat, global bazda bütün organik maddeler bozunmamaktadır. Dolayısıyla atmosferde bol miktarda oksijen bulunmaktadır. Eğer bir sistemdeki doğal dönüşüm hızı ve ekolojik denge kirlenmeden dolayı ters yönde etkilenirse, bunun sonucunda bütün sistem kötü yönde etkilenmiş olur. Bir nehrin “kendi kendini temizleme” kapasitesi yetersiz kalabilir ve balık avlama alanları tahrip olabilir; bir nehir besin yönünden çok fazla zenginleşebilir ve dolayısıyla ötrofikasyona uğrayabilir; kirlenmiş toprak gözenekli özelliğini ve nem tutma kapasitesini kaybederek tarım için uygun olmayan bir hale dönüşebilir.
EKOSİSTEM DENGESİ
Abiyotik (Canlı Olmayan) Öğeler
![]() İklim
İklim
- Sıcaklık
- Nem ve Yağış
- Işık
- Rüzgar
![]() Jeomorfoloji
Jeomorfoloji
![]() Sular
Sular
![]() Toprak
Toprak
Biyotik (Canlı) Öğeler
![]() Üreticiler
Üreticiler
- Bitkiler
- Algler
- Kara Yosunları
- Bakteriler
![]() Tüketiciler
Tüketiciler
- Herbivorlar (Otçullar)
- Karnivorlar (Etçiller)
- Omnivorlar (Hem Otçul Hem Etçil)
![]() Ayrıştırıcılar
Ayrıştırıcılar
- Bakteriler
- Mantarlar
Ekolojik toplumun büyüklüğü ve tipi, o çevredeki karmaşık fiziksel, kimyasal ve biyolojik şartlara bağlıdır. Bir organizmanın verilen şartlara toleransı, bu organizmanın ekosistemdeki dağılımı ve göreceli olarak baskınlığı üzerinde etkili olmaktadır.
Herhangi bir besin seviyesindeki besin üretiminin hızı ve miktarı, bir üst seviyedeki tüketicilerin sayısı ve çeşidi üzerinde etkili olmaktadır. Eğer tüketici çeşidi çoksa (türlerin farklılığı çoksa), besin zinciri de daha kompleks olur. Bu durum, bir organizmayı sadece tek besin kanalına bağımlı olmaktan kurtarır ve sistemin daha dengeli olma şansını artırır.
Organik atıkların akarsulara veya su birikintilerine verilmesi, uygun olmayan bir çevre oluşmasına ve balık türlerinin azalmasına sebep olabilir. Uygun olmayan çevre şartları, göreceli olarak daha hassas olan türlerin azalmasına, daha dayanıklı türlerin ise yaşamlarını sürdürüp çoğalmalarına yol açar. Eğer yeterli besin varsa fakat çevre şartları uygun değilse, sadece dayanıklı türler içerisindeki birey sayısında artış olur, tür çeşitliliğinde ise azalma olur.
Kirleticilerin Özellikleri
Bir ekosisteme giren çeşitli kirleticiler, aşağıdaki üç gruptan birisine dahildir:
![]() Bozunabilir
Bozunabilir
![]() Bozunmayan (Konservatif)
Bozunmayan (Konservatif)
![]() Biyolojik olarak biriken (Süreğen)
Biyolojik olarak biriken (Süreğen)
Bozunabilir kirleticiler, kanalizasyon suyu gibi kompleks organik maddeler ve derece derece mikrobik bozunmaya uğrayan ölü organizmalardır. Bozunabilir maddeler, aynı zamanda fiziksel bozunmaya ve çürümeye uğrayan maddeleri de içerir. Organik maddelerin mikroplar vasıtasıyla bozunmaya uğraması oksijen tüketimine neden olur.
Bozunmayan (konservatif) maddeler, biyolojik etkilere karşı inert yapıdadırlar. Bu grupta inorganik kimyasal maddeler (klorin, vb.), ağır metaller (civa, kurşun, vb.) ve bazı inatçı organik maddeler (PCB, DDT, vb.) yer almaktadır.
Biyolojik olarak biriken maddeler, besin zincirinde birikmeye müsait maddelerdir. Bunlar arasında civa, kadmiyum, arsenik, kurşun, manganez, pestisidler (haşere ilaçları) ve radyoaktif izotoplar sayılabilir.
Kirleticilerin Etkileri ve Kontrolü
Çevreyi oluşturan toprak, su ve gaz fazları arasında sınırlar bulunmamaktadır. Bir fazda oluşan kirlenme, gelecekte başka bir faza da transfer olabilir. Kirleticiler ya zamanla bozunurlar ya da inert bir yapı göstererek bozunmadan kalırlar. Kirleticilerin kontrolü, sadece atıkların arıtılması değil, aynı zamanda toplam maliyetin en az olması felsefesine dayalıdır. Kirleten Öder Prensibi’nin benimsenmesi önemlidir.
Meskenlerden, endüstriden ve ziraî faaliyetlerden doğan artıklar, su kaynaklarını etkiler. İndirgeyici kimyasal maddeler, suyun oksijenini ani olarak tüketirler. Organik maddelerin ayrışması, oksijenin yavaşça tükenmesine neden olur. Oksijenin azalması, suda yaşayan canlıların hayatını olumsuz etkiler. Şilt, çamur ve maden artıkları, suyun bulanıklığını artırır ve fotosentezi engeller. Asitler, alkaliler ve zehirli maddeler, su hayatına zarar verir. Ağır metaller (civa gibi), besin zincirlerinde konsantrasyonları artarak zararlı hale gelir.
Tuzlar, içme ve sulama sularında istenmez. Fosfatlar ve azot tuzları, alglerin aşırı üremesine neden olur. Fosfatlar, genellikle sentetik deterjanlardan ve zirai alanlardan sulara karışır. Amonyak azotu, çiftliklerden yüzey sularına karışır. Organik bileşiklerdeki azot, atık su arıtma tesislerinde inorganik azot haline dönüşür.
Köpük ve yüzücü maddeler, suya hoş olmayan bir görünüm verir. Su sıcaklığının yükselmesi, kirliliğin etkilerini artırır. Endüstriyel atıklarda fenol, kadmiyum, krom, kurşun ve manganez bulunabilir. İnorganik azot ve fosforun giderilmesi zor ve pahalıdır. Erimiş tuzların giderilmesi için elektro-diyaliz, ters ozmoz, iyon değiştirme gibi pahalı metotlar kullanılır.

Atık su Karakteristikleri
Evsel atık sular, askıda, koloidal ve çözünmüş halde organik ve inorganik maddeler içerir. Atık suyun konsantrasyonu, kullanılan suyun orijinal konsantrasyonuna ve kullanım amacına bağlıdır. İklimsel şartlar, yaşam standartları ve kültürel faktörler, atık su karakteristiğini önemli ölçüde etkiler.
Endüstriyel atıkların evsel kanalizasyonlara karışması, atık su özelliklerini önemli ölçüde değiştirir. Konsantrasyonlar, kişi başına günlük su kullanımına bağlı olarak değişir. Atık su karakteristikleri, şehirden şehre, mevsimden mevsime ve hatta saatten saate değişkenlik gösterir.
Atıklar, büyük oranda karbon, azot, fosfor gibi organik besinlerden ve yüksek konsantrasyonda mikroorganizmalardan oluşur. Bu maddeler, hemen çürümeye müsait olup, kanallarda akarken bile biyolojik bozunmaları devam eder. Bu süreç, atık suyun bazı özelliklerinin zaman içinde değişmesine neden olur.
Biyolojik Olarak Ayrışabilirlik
Kirleticiler, organizma ve ekosistemlerde uzun süre kalabilme veya kısa sürede ayrışıp parçalanabilme özelliklerine göre sınıflandırılabilir. Evsel atık sular ve bazı sentetik organik kimyasal maddeler, genellikle parçalanabilir veya ayrıştırılabilir kirletici sınıfına girer. Bu tür kirleticilerin kontrolü, sistemin aşırı yüklenmesini önleyerek yapılır.
Ancak, ayrıştırılamayan kirleticiler, doğal arıtım mekanizmaları ile parçalanamaz. Bu gruba metaller, ağır metal tuzları, çökeltiler, bazı bakteri ve virüsler ile bazı sentetik organik kimyasal maddeler (deterjanlar gibi) dahildir. Bu kirleticiler, ileri atık su arıtma metotları ile giderilir veya çevreye girişleri önlenerek kontrol edilir. EM (Etkili Mikroorganizmalar), deterjanlar, ağır metaller ve pestisitler gibi kirleticilerin arıtımını sağlayabilmektedir.

Biyolojik Mekanizma
Suların kirlenmesine sebep olan maddelerin büyük bir kısmı organik orijinlidir. Bu maddeler, canlı varlıkların ölmesi sonucu ortaya çıkan ölü organik maddeler veya endüstriyel atıklar olabilir. Bu maddelerin indirgenmesi ve ayrıştırılması sırasında, canlı organizmalar aktif rol oynar.
Bu süreçler iki ana kategoriye ayrılır:
![]() Aerobik ayrışma veya biyokimyasal oksidasyon: Oksijenin mevcut olduğu durumlarda gerçekleşir.
Aerobik ayrışma veya biyokimyasal oksidasyon: Oksijenin mevcut olduğu durumlarda gerçekleşir.
![]() Anaerobik ayrışma veya havasız ayrışma: Oksijenin bulunmadığı durumlarda gerçekleşir.
Anaerobik ayrışma veya havasız ayrışma: Oksijenin bulunmadığı durumlarda gerçekleşir.
Bu olaylarda, organik maddelerin temel unsurları olan karbon (C), azot (N) ve kükürt (S) sürekli bir dönüşüme uğrar. Bu süreçler, çevrimsel olaylar olup, maddeler çeşitli değişikliklere uğradıktan sonra tekrar başlangıç formlarına dönerler.
Aerobik Ayrışma (Havalı Ayrışma)
Aerobik ayrışma, oksijenin mevcut olduğu durumlarda, mikro ve makro organizmalar tarafından gerçekleştirilir. Bu organizmalar, organik maddeleri hücre yapımında kullanır ve enerji elde eder. Bu süreçte, organik maddelerin bir kısmı hücre yapısına dahil edilirken, diğer kısmı CO₂‘ye dönüştürülerek enerji üretimi için kullanılır. Bu olaya biyokimyasal oksidasyon veya ıslak yanma da denir.
Tabiatta bu tür bir ayrışmanın gerçekleşmesi, doğal dengenin bozulduğunu gösterir ve suni arıtma yöntemleri kullanılmasını gerektirir. Bu yöntemlerde, doğal süreçler tasfiye tesislerinde hızlandırılır. Suya dışarıdan hava verilir veya havalandırma düzenleri ile türbülans yaratılarak oksijen sağlanır. Ayrıca, atık sular taneli malzeme yığınları içinden geçirilerek havalandırılır.
EM (Etkili Mikroorganizmalar), hem aerobik hem de anaerobik koşullarda arıtma yapabilme yeteneğine sahiptir. Bu, EM’nin hem havalı hem de havasız ortamlarda etkili olduğunu gösterir.
Anaerobik Ayrışma (Havasız Ayrışma)
Anaerobik ayrışma, oksijenin bulunmadığı durumlarda gerçekleşir. Bu süreçte, organik maddeler, ölü organizmalar ve endüstriyel atıklar gibi maddelerdeki karbon (C), azot (N) ve kükürt (S) sürekli olarak indirgenir. İlk aşamada organik asitler, karbonik asit, karbondioksit, hidrojen sülfür ve amonyak gibi maddeler oluşur. Son aşamada ise bu maddelerin indirgenmesiyle metan gazı meydana gelir. Bu süreçte, amonyak, karbondioksit ve hidrojen sülfür gibi gazlar sürekli olarak açığa çıkar ve atmosfere karışır. Geriye çürümüş çamur (humus) kalır. Bu durum, suyun aşırı derecede kirlendiğinin bir göstergesidir.
EM (Etkili Mikroorganizmalar) ile anaerobik ayrışma sürecinde ise, bu olay tersine çevrilir. EM, antioksidasyon ortamı yaratarak, zararlı ve kötü kokulu gazlar yerine karbondioksit gazı ve azot gazı gibi nötr ürünlerin oluşmasını sağlar. Bu, atmosferin %79’unu oluşturan azot gazının açığa çıkmasıyla sonuçlanır.

Akarsu Kirliliği
Akarsular, göller ve denizler, yerüstü sularını oluşturur. Dünya nüfusunun hızla artmasına rağmen su kaynaklarının sabit kalması, bu kaynakların kirletilmemesini ve verimli kullanılmasını gerektirir. Bilinçli su kullanımı ve basit tedbirlerle, su kaynaklarının kirlenmesini ve tükenmesini önleyebiliriz.
Ülkemizde, evsel ve endüstriyel atıklar, su kaynaklarını ciddi şekilde kirletmektedir. Atıkların arıtılmadan su yataklarına verilmesi, katı atıkların düzensiz bırakılması, bilinçsiz zirai ilaçlama ve gübreleme, yerüstü sularının kirlenmesine neden olmaktadır. Sanayi, çevre üzerinde diğer faktörlerden daha fazla olumsuz etkiye sahiptir. Sanayi atıkları, su kirliliğine, toprak ve bitki örtüsünün bozulmasına ve doğal tahribata yol açar.
Köyden kente göç ve hızlı, düzensiz yapılaşma, çevre kirliliğini artırmaktadır. Tarım ilaçları ve kimyasal gübrelerin bilinçsiz kullanımı, toprağı çoraklaştırmakta ve yeraltı sularına sızarak su kirliliğine neden olmaktadır. Akarsular, kanalizasyon suları, fabrika atıkları, tarımsal kimyasallar gibi etkenlerle kirlenmektedir.
Akarsular ve okyanuslar, belirli bir seviyeye kadar kirliliği arıtabilir. Ancak bu sınır aşıldığında, aşırı kirlilik ve ekolojik denge bozulması başlar. Bu durum, bitkiler, hayvanlar ve insanlar üzerinde olumsuz etkilere yol açar.

Göl Kirliliği
Bir gölün anaerobik hale geçmesinde, gölün asimilasyon kapasitesi büyük önem taşır. Ötrofikasyon (ikincil kirlenme), fosforca zengin evsel atık sular, tarımsal drenaj suları ve bazı endüstriyel atık suların göllere karışmasıyla ortaya çıkar. Bu durum, aşırı alg üremesine, organik madde miktarının artmasına ve kimyasal değişikliklere neden olur.
Endüstriyel ülkelerde, her yıl birçok balık ölümü vakası yaşanmaktadır. Bu ölümlerin %50-75’i endüstri ve yerleşim bölgelerinden, %10’u ise haşere ilaçlarının yağmur sularıyla yüzeysel sulara karışmasından kaynaklanır. Oksijen tüketen atıklar ve kısa ömürlü zehirli maddeler, su ile seyreltme yöntemiyle çözülebilir. Ancak radyoizotoplar, ağır metaller, DDT, PCB gibi yavaş ayrışan kimyasallar ve petrol gibi maddeler için bu yöntem etkili değildir. Bu maddelerin nehir ve akarsulara girişi engellenmelidir.
Akarsu kirliliğinin önlenmesi, sadece bireysel tesislerin deşarjlarını kontrol etmekle değil, tüm havzayı kapsayan bir sistemle ele alınmalıdır. Nehir suları birkaç haftada yenilenirken, göl sularının yenilenmesi birkaç yıldan yüz yıla kadar sürebilir. Sığ göllerin temel problemi, evsel ve endüstriyel atıklar ile tarımsal yağış sularının neden olduğu aşırı beslenme ve bunun sonucunda ortaya çıkan istenmeyen gelişmelerdir. Bu durum, ötrofikasyon olarak adlandırılır ve özellikle göllerde görülür, ancak yavaş akan akarsular ve nehir ağızlarında da görülebilir.
Bir gölün anaerobik hale gelmesinde, gölün asimilasyon kapasitesi önemli bir rol oynar. Ötrofikasyon, fosforca zengin evsel atıklar, tarımsal drenaj ve bazı endüstriyel atıkların göllere karışmasıyla başlar. Bu durum, aşırı alg üremesi, organik madde artışı ve kimyasal değişikliklere yol açar.
Endüstriyel ülkelerde her yıl birçok balık ölümü vakası görülür. Bu ölümlerin %50-75’i, endüstri ve yerleşim alanlarından kaynaklanırken, %10’u haşere ilaçlarının yağmurla suya karışmasından ortaya çıkar. Oksijen tüketen atıklar ve kısa ömürlü zehirli maddeler suyla seyreltilebilir, ancak radyoizotoplar, ağır metaller, DDT, PCB ve petrol gibi yavaş ayrışan maddeler için bu yöntem etkili değildir. Bu maddelerin akarsulara girmesi engellenmelidir.
Akarsu kirliliği yalnızca bireysel deşarjların kontrolüyle değil, tüm havzayı kapsayan bir sistemle önlenmelidir. Nehir suları birkaç haftada yenilenirken, göl suları yıllar veya yüzyıllar süresince yenilenebilir. Sığ göllerin temel sorunu, evsel ve endüstriyel atıklar ile tarımsal yağış sularının aşırı besin yüklemesi yaparak istenmeyen gelişmelere yol açmasıdır. Bu durum, ötrofikasyon olarak adlandırılır ve özellikle göllerde görülür, ancak yavaş akan akarsularda ve nehir ağızlarında da görülebilir.
Atıksuda EM® Kullanımı
Atıksu arıtma tesislerinde biyolojik arıtma sırasında mikroorganizmaların kullanımı yaygındır ve doğada da atıksular yine mikroorganizmalar tarafından temizlenir. Ancak, biyolojik arıtma, organik kirleticilerin doğada yok edilmesini sağlayan biyoflokülasyon ve mineralizasyon süreçlerinin kontrollü bir ortamda ve optimum koşullarda tekrarlanmasından ibarettir. Bu işlem, seçilen mikroorganizmaların kullanımıyla yapılır. Geleneksel arıtma yönteminde, sadece bazı mikroorganizmalar kullanılarak organik madde parçalanır, ancak nihai su kalitesini artıracak diğer mikroorganizmaların kullanımına dair bir yaklaşım bulunmaz.
Etkin Mikroorganizmaların (EM) kullanımı, anaerobik arıtma yapılmasına olanak tanır. Ancak, EM’nin yalnızca anaerobik koşullarda etkili olduğu düşünülmemelidir, çünkü EM hem aerobik hem de anaerobik koşullarda etkindir. Bu nedenle, geleneksel atıksu arıtma sistemlerinde, biyolojik reaktör dışındaki tüm arıtma aşamalarında EM kullanılmasının faydalı olacağı söylenebilir. EM’nin ürettiği bazı kimyasal maddeler, laktik asit, antioksidanlar ve enzimler, sağladığı faydanın önemli bir kısmını oluşturur.
EM.1®’den EM.A® üretimi sırasında fermantasyon gerçekleştirilir ve üretilen EM.A® atıksuda kullanıldığında, atıksu için faydalı çeşitli bileşikler oluşur. Bu bileşikler arasında yüksek hidrolitik etkinliğe sahip enzimler ve antioksidan maddeler bulunur. Bu bileşikler, EM mikroorganizmaları ile birlikte atıksuyun yüksek verimlilikle arıtılmasını sağlar. Arıtmada EM kullanımını değerlendirirken, su ve çamurun ayrı ayrı ele alınması gerektiği unutulmamalıdır.

SU
Katı maddelerin ayrıştırılması
Organik çökeltiler, EM® ile yapılan fermantasyon sonucu dekompozisyona uğrayarak bozulur. Bu işlemle, organik partiküllerin boyutu kolloidal madde boyutunun altına iner. Ayrıca, fermantasyon sayesinde kötü koku oluşumu engellenir.
EM.1®‘den EM.A® üretimi sırasında fermantasyon, aynı zamanda şekerlerle yapılan fermantasyonu da içerir. Bu süreç sonucunda, EM.A® içinde ekzoenzimler ortaya çıkar ve bu enzimler mikroorganizmaların büyümesi için gerekli olan besinleri sağlar. Fermantasyon tamamlandığında, EM.A®’da organik maddeleri hidrolize edecek mikroorganizmalar ve enzimler bulunur.
Suyun Kalitesinin Değişmesi
Organik madde çökeltilerinin su içinde çözünmesi, iki aşamada iki farklı etki yaratır. İlk aşamada, kısa bir süre için suyun kalitesi kötüleşir. Bu süre zarfında, Miselis (Mycelis) gibi öğeler zararlı gibi görünebilir, ancak panik yapmaya gerek yoktur çünkü bu maddeler su içindeki mikroorganizmalar tarafından kısa sürede kullanılacaktır. Çözünmüş organik madde içeriğindeki artış, mikroorganizmalar için besin kaynağı sağlar ve bu durum biyolojik reaktörün işleyişinde iyileşmelere yol açar.
Su Türbülansında İyileşme
Yukarıda belirtilen koşullara yaklaşık bir hafta içinde ulaşılır ve bu süreçten sonra suyun türbülansında iyileşme gözlemlenir. Ancak, lifli veya inorganik madde miktarı fazla ise, bu sürece ulaşmak daha uzun sürebilir. Değişim tamamlandıktan sonra, organik madde ya çözünecek ya da çökelecektir, ancak miktarı daha az olacaktır. Çökelen organik maddenin uzaklaştırılmaması gerektiği unutulmamalıdır, çünkü bu madde, EM® (Etkin Mikroorganizmalar®) üreten bir kaynak olarak görev yapar ve organik maddenin dekompozisyonunun devamında temel rol oynar. Bu sayede, arıtılan suyun temiz ve yüksek kalitede olması sağlanabilir.
Dinamik arıtma sistemlerinde (neredeyse tamamı böyledir), çökelen maddenin bir kısmı suyun yüzeyine çıkarak bir sonraki arıtma aşamasına sürüklenebilir. EM® genellikle ön arıtma aşamasında (büyük katıların, yağların ayrıştırılması vb.) kullanılır. Yüzen bu maddeler, ya biyolojik reaktörde kullanılacak ya da birinci veya ikinci durultucularda çökelecektir.
Antioksidasyonun Teşvik Edilmesi
EM® uygulanmaya başlandıktan sonra, birkaç hafta içinde özellikle oksidasyon nedeniyle çözeltideki iyonlaşmanın baskılanması sağlanır. Oksidasyon, iyonlaşmayı teşvik ederken, EM® ilavesiyle fermantasyon ve dolayısıyla antioksidasyon, iyonik halin indirgenmesini teşvik eder. Bu durum, atıksuyun kalitesine bağlı olarak, eğer iyonik halde yüksek miktarda kirletici madde bulunuyorsa, çökelme miktarında bir artışa yol açabilir.
Bu etki, özellikle maden ocaklarında biriken sulardaki iyonların uzaklaştırılmasında, deri sanayi atıklarında bolca bulunan Cr+6‘nın çevreye zararsız hale getirilmesinde ve metal kaplama sanayi atıksularındaki ağır metallerin arıtılmasında son derece yararlıdır.
Kötü Kokunun Yok Edilmesi
Kötü kokunun giderilmesi, iki ana nedene dayanır:
- EM®, organik maddeyi kontrol altına alarak, fermantasyon yoluyla bozunmasını sağlar. Bu, kokuşma (putrefaction) ve çürümeyi engeller. Kokuşma sırasında, amonyak ve hidrojen sülfit (H₂S) gibi uçucu bileşikler üreten mikrobiyal flora kontrol altına alınır. Böylece, kükürt indirgeme yoluyla H₂S üreten, amonyak üreten veya çürüme sürecini başlatan bakteri sporları (örneğin, Clostridium spp.) engellenir.
- Fotosentetik bakteriler, biyolojik oksidasyon yoluyla H₂S ve kükürt (S) elementinin asimilasyonunu sağlar. EM® içindeki fotosentetik bakterilerin yüksek konsantrasyonu, H₂S’in açığa çıkmasını ve dolayısıyla kötü kokuları önler. Bu durum, merkaptanlar ve kükürt grupları gibi diğer S türevleri için de geçerlidir.
Amonyak söz konusu olduğunda, EM® içindeki nitrifiye edici bakteriler, nitrifikasyon sürecini hızlandırarak amonyağın uçucu hale gelmesini engeller. Hem H₂S hem de amonyak, besin kaynağı olarak kullanıldıkları için, asimilasyonları sonucunda konsantrasyonları azalır ve bu da kötü kokuların yok edilmesine katkı sağlar.
Ayrıca, EM®’nin antioksidan etkisi, yağların bozunması sırasında oluşan ve kötü kokulardan sorumlu olan diğer bileşiklerin ortaya çıkmasını engeller.

ÇAMUR
Çamurun işlenmesi sırasında, anaerobik koşullar geçerlidir. Bu koşullarda EM uygulandığında, normal sindirim (digestion) süreci hızlandırılır ve çamurun kararlılığı (stabilitesi) artar. Bir sindirim tankında (digestor) iki kademeli bir süreç bulunmaktadır.
Birinci kademede, mikrobiyolojik kütle gibi kompleks organik maddeler, fermantasyon yoluyla yağlı asitler, CO₂ ve H₂’ye dönüşür (büyük moleküller hidrolize olur). Bu süreçte, büyük miktarda anaerobik, ancak metanojenik olmayan bakteriler rol oynar. Bu, EM‘nin sindirimin birinci kademesinde önemli bir rol oynayacağı anlamına gelir.
Çeşitli bileşiklerde meydana gelen biyolojik değişimler aşağıdaki yönde hızlanacaktır:
- Proteinler → Aminoasitler → NH4+
- Yağlar → Yağlı asitler → Asetat
- Yağlar → Gliserol → Organik Asitler
- Organik Asitler → Basit Şeker → Kompleks Şeker
İkinci aşamada, metil ve metan gruplarının doğrudan indirgenmesiyle ya da CO2‘in hidrojenle, yağlı asitler ve metanol gibi fermantasyon sonucu indirgenmiş diğer ürünlerle ya da mevcut karbonmonoksit ile doğrudan indirgenmesiyle metan üretilmektedir.
EM®’nin çamur üzerindeki önemli etkilerinden biri, yukarıda bahsedilen mekanizmalar sayesinde kötü kokuların yok edilmesidir. Ayrıca, partikül boyutunun küçülmesi nedeniyle çamur hacminde önemli bir azalma gözlemlenir.
Havalandırma Hacminde Azalma (O₂ Tüketimi)
EM® mikroorganizmaları, anaerobik koşullarda organik maddenin bozunmasında etkinlik sağlar. Bu, organik kütlenin oksidasyonu için gerekli oksijen miktarında azalmaya neden olur. Biyolojik reaktöre giren atıksuda hidrolize olmuş organik madde bulunması, reaktördeki mikroorganizmaların sindirebileceği organik madde akışını sürekli hale getirir.

Sanayi ve Evsel Atıksu Arıtma Tesislerinde EM® Kullanımı
- EM®, hem aerobik hem de anaerobik koşullarda etkilidir. Aerobik arıtma sistemlerinde, dinlendirme veya çökeltme havuzlarında kısmen anaerobik koşullar bulunur. EM®, bu koşullarda daha iyi çalışır ve kokuşmayı önler. Biyolojik reaktörde 1-2 ppm çözünmüş oksijen bulunması önemlidir; aksi takdirde, mikroorganizmalar değişebilir ve arıtma verimi düşebilir.
- EM®, birincil ve ikincil çökeltme tanklarında ve çamur sindirme ünitesinde etkilidir. Sedimentasyon hızını %25-50 artırır ve çamur sindirim süresini %10-20 azaltır. Bu değerler, proses kontrolüne göre değişebilir.
- Dozajlama, yarım dozla başlamalı ve 4-6 hafta içinde kademeli olarak artırılmalıdır. Bu, biyolojik reaktördeki mikroorganizmaların EM® ile uyum içinde çalışmasını sağlar. Acele dozajlama, katı madde oranının artmasına ve biyolojik reaktörde şişme (bulking) sorununa yol açabilir.
- H₂S, merkaptanlar ve amonyak gibi gazların kontrolü önemlidir. EM®, kötü kokuları %95 oranında azaltır ve hidrojen sülfit ile amonyak gazı çıkışını önemli ölçüde düşürür. EM®, koku azaltmada oldukça etkilidir.

Evlerde ve Turistik Amaçlı EM® Kullanımı
EM®, evlerde, otellerde ve diğer yerlerde çeşitli amaçlarla kullanılabilir. En yaygın kullanım alanları ve şekilleri şunlardır:
Evlerde:
![]() Banyo, lavabo ve tuvaletlerde hijyen sağlamak ve kötü kokuları yok etmek için kullanılabilir.
Banyo, lavabo ve tuvaletlerde hijyen sağlamak ve kötü kokuları yok etmek için kullanılabilir.
![]() Foseptik çukurlarına uygulanabilir.
Foseptik çukurlarına uygulanabilir.
Otellerde:
![]() Kötü kokan alanlarda (merdiven altı, boşluklar gibi) ve odalarda (ardiyeler gibi) kötü kokuların giderilmesinde etkilidir.
Kötü kokan alanlarda (merdiven altı, boşluklar gibi) ve odalarda (ardiyeler gibi) kötü kokuların giderilmesinde etkilidir.
![]() Küf kokusu olan nemli veya havasız yerlerde kötü kokuları yok etmede kullanılır.
Küf kokusu olan nemli veya havasız yerlerde kötü kokuları yok etmede kullanılır.
![]() Lokanta ve otellerde, paket arıtma sistemlerinin yetersiz kaldığı durumlarda başarıyla uygulanır. KOİ, BOİ ve AKM değerlerini azaltır.
Lokanta ve otellerde, paket arıtma sistemlerinin yetersiz kaldığı durumlarda başarıyla uygulanır. KOİ, BOİ ve AKM değerlerini azaltır.
Diğer Yerlerde:
![]() Otel ve kamplarda, su kalitesini iyileştirmek ve kötü kokuları gidermek için kullanılır.
Otel ve kamplarda, su kalitesini iyileştirmek ve kötü kokuları gidermek için kullanılır.
Sonuç olarak:
Atıksuda EM® kullanımı, aşağıdaki avantajları sağlar:
- Kötü kokuların yok edilmesi ve organik madde sedimentasyon (çökelme) hızının artırılması.
- KOİ, BOİ ve AKM değerlerinin azaltılması.
- Anti-oksidasyon etkisi ile iyonlaşmanın bastırılması.
EM® kullanıldığında, O₂ tüketimi azalır, bu da işletme maliyetlerini düşürür. Arıtılmış suda hala EM® mikroorganizmaları bulunur, bu nedenle atıksu doğaya deşarj edildiğinde bitki örtüsü ve çevre kalitesinde önemli bir iyileşme gözlenir. Bu iyileşme, suyun biyolojik kalitesinin artmasının bir sonucudur.
EM® Prosesi
EM®, içinde çok sayıda ve çeşitli mikroorganizmalar barındırır. Bu mikroorganizmalar, birbirleriyle yarışmadan ve baskın çıkmadan, birbirlerini destekleyerek birlikte yaşarlar. Bir mikroorganizmanın salgıladığı madde, diğeri için besin oluşturur.
- Fermentasyon mikroorganizmaları, fotosentez bakterileri için mükemmel gıdalar üretir.
- Fotosentez bakterileri tarafından salgılanan ATP, diğer mikroorganizmalar tarafından kullanılarak mikroorganizma büyümesi sağlanır.
- Fotosentez bakterileri, serbest elektronları yakalayarak atıksu içinde bir antioksidasyon alanı yaratır. Bu alan, iyonlaşma prosesini bastırır ve patojenlerin çoğalmasını engeller.
Atıksu arıtma tesisinde, flokülasyon ve çökelmede artış gözlenir. Atıksu temizlenir ve mikroorganizmalar tarafından antioksidan maddeler salgılanır.
EM®'in Kullanıldığı Yerler:
- Atıksu arıtma tesisleri
- Çöp aktarma istasyonları
- Kentsel katı atık taşıma araçları ve bunların yıkama suları
- Şehir kanalizasyon ağları ve bacaları
- Katı atık deponi alanları
- Terfi istasyonları
- Kanalizasyon ve foseptikler
- Açık kanal şeklinde akan dereler
- Çöp sızıntı suları
- Kompost tesisleri
- Hayvan barınakları
- Küçük ve büyükbaş hayvan çiftlikleri
- Çöp odaları
- Çöp taşıma araçları ve konteynerleri
- Çöp işleme tesisleri
- Sintine temizliği (Tekne ve gemiler)
- Balık işleme tesisleri
- Mezbahalar ve et kombinaları
- Yağ tutucular
- Atık lagünleri
- Her türlü koku giderimi
- Mutfak ve banyo giderleri
- Gübre yığınları
- Gübre çukurları
- Karada ve suda yağ döküntüleri
- KOİ, BOİ, yağ ve greslerin giderimi
- Petrol rafineleri ve maden alanları
- Kirlenmiş toprakların rehabilitasyonu
- Deniz, dere, nehir, göl rehabilitasyonu
- Biyolojik ve yapay gölet rehabilitasyonu
- Dev akvaryumlar
- Botanik göl iyileştirilmesi (sucul bitkilerin sağlıklı büyümesi ve yosunlaşmanın giderilmesi)

EM’in Çalışma Mekanizmaları
biyofilm
EM®’nin su havzalarındaki etkisini anlamak için, mikroorganizmaların yaşama tutunma mücadelesi ve biyofilm oluşumu sürecini incelemek gerekir. Biyofilm, mikroorganizmaların kendi salgıladıkları yapışkan bir madde içinde birbirlerine veya yüzeylere tutundukları bir yapıdır. Örnekler arasında diş plakları, dere taşlarındaki kaygan tabaka ve vazoların iç yüzeyindeki tabaka bulunur. Biyofilm, su ile temas eden her yüzeyde oluşur ve yüzeye sıkıca yapışır, bu nedenle uzaklaştırılması zordur.
- Biyofilmler, tek bir mikroorganizma türü veya birden fazla tür tarafından oluşturulabilir. Farklı türlerden oluşan biyofilmlerde, her tür kendi mikrokolonisini oluşturur ve bu koloniler su kanalları ile birbirinden ayrılır. Bu kanallar, besin maddeleri ve oksijenin difüzyonunu sağlar (bazı mikroorganizmalar oksijene ihtiyaç duymaz).
- Su havzalarında, özellikle akarsularda, serbest yüzen biyofilmlere de rastlanır. Mikroorganizmalar, hücre dışı polimerik madde (EPS) adı verilen bir matriks içine yerleşir. EPS, hücre dışı DNA, proteinler ve polisakaritlerden oluşan bir yapıdır ve sümüksü madde olarak da adlandırılır (ancak her sümüksü madde biyofilm değildir).
- Biyofilmler, canlı veya cansız yüzeylerde oluşabilir ve doğal ortamda mikrobiyal yaşamın en önemli göstergesidir.

biyofilm oluşumu
Biyofilm oluşumu, serbest yüzen mikroorganizmaların bir yüzeye tutunmasıyla başlar. Bu yüzey, taş, kil, çamur, yaprak, dal veya akarsulardaki bez parçası gibi yabancı cisimler olabilir. İlk koloniler, Van Der Waals adhezyon kuvvetleri ile yüzeye zayıf ve tersinir olarak bağlanır. Eğer bu koloniler yüzeyden ayrılmazsa, pili gibi yapılar aracılığıyla yüzeye kalıcı olarak tutunurlar.
- İlk koloniler, diğer hücreleri çekerek koloniyi büyütür ve biyofilmi bir arada tutacak matriksi inşa etmeye başlar. Bazı mikroorganizmalar, doğrudan yüzeye yapışamaz ancak önceden oluşmuş kolonilere veya matrikse tutunabilir.
- Kolonileşme sırasında, hücreler birbirleriyle iletişim kurar. Bu iletişim, biyofilmin sağlamlığını ve besin paylaşımını sağlar.
- Biyofilm, hücre bölünmesi ve akarsudan yeni hücrelerin eklenmesiyle büyümeye devam eder. Son aşamada, biyofilm tamamen oluşur ve sadece şekli ve boyutu değişebilir.
Biyofilm Oluşumunun Aşamaları
Biyofilm gelişimi, beş ana aşamadan oluşur:
![]() İlk Tutunma: Mikroorganizmalar, bir yüzeye zayıf ve tersinir bir şekilde tutunur.
İlk Tutunma: Mikroorganizmalar, bir yüzeye zayıf ve tersinir bir şekilde tutunur.
![]() Tersinir Olmayan Tutunma: Mikroorganizmalar, yüzeye kalıcı olarak tutunur ve koloni oluşturmaya başlar.
Tersinir Olmayan Tutunma: Mikroorganizmalar, yüzeye kalıcı olarak tutunur ve koloni oluşturmaya başlar.
![]() Olgunlaşma I: Koloniler büyür ve matriks oluşumu başlar.
Olgunlaşma I: Koloniler büyür ve matriks oluşumu başlar.
![]() Olgunlaşma II: Biyofilm, olgun bir yapıya dönüşür ve mikroorganizmalar arasında iletişim artar.
Olgunlaşma II: Biyofilm, olgun bir yapıya dönüşür ve mikroorganizmalar arasında iletişim artar.
![]() Saçılma: Biyofilmden bazı hücreler ayrılarak yeni koloniler oluşturmak üzere dağılır.
Saçılma: Biyofilmden bazı hücreler ayrılarak yeni koloniler oluşturmak üzere dağılır.

Saçılma
Saçılma, biyofilm kolonilerinden hücrelerin ayrılarak yeni yüzeylere yayılması sürecidir. Bu, biyofilmin yaşam döngüsünün önemli bir aşamasıdır. Saçılma sırasında, biyofilmi bir arada tutan polimer matriks, dispersin B ve deoxyribonuclease gibi enzimler tarafından parçalanır. Bu enzimler, hücrelerin yeni yüzeylere kolonize olmasını sağlar.
EM® ile Kötü Kokuların Yok Edilmesi
Kirlenmiş su havzalarında, başlıca kirlilik kaynağı aşırı organik madde birikimidir. Normalde, mikroorganizmalar organik atıkları parçalayabilir, ancak atık miktarı arttığında sorunlar ortaya çıkar.
![]() Başlıca Organik Yük: Karbonhidratlar ve proteinlerden oluşur.
Başlıca Organik Yük: Karbonhidratlar ve proteinlerden oluşur.
![]() Oksidasyonla Parçalanma: Organik madde, oksijen kullanarak aşağıdaki şekilde parçalanır:
Oksidasyonla Parçalanma: Organik madde, oksijen kullanarak aşağıdaki şekilde parçalanır:
- Karbonhidratlar → Karbondioksit + Su
- Proteinler → Amino asitler → Amonyak → Nitrit → Nitrat
Bu reaksiyonların devam etmesi için erimiş oksijen gereklidir. Ancak, organik madde yükü çok yüksek olduğunda, erimiş oksijen tükenir ve reaksiyonlar tamamlanamaz. Bu durumda, kokuşma (pütrifikasyon) başlar ve hidrojen sülfit (H₂S) ile amonyak (NH₃) gibi zararlı ve kötü kokulu bileşikler oluşur.
EM®, bu süreci engeller. EM® ilavesi, organik maddenin fermantasyon yoluyla parçalanmasını sağlar ve antioksidan maddeler, doğal vitaminler, doğal antibiyotikler ve biyolojik aktif maddeler gibi faydalı bileşiklerin oluşumuna yol açar. Bu sayede, zararlı ve kötü kokulu gazların oluşumu önlenir.

EM® ile Kötü Kokuların Yok Edilmesi ve Miselyumun Rolü
EM® uygulandığında, kokuşarak parçalanma süreci fermantasyon yoluyla parçalanmaya dönüşür. EM®, organik maddeyi kontrol altına alır ve oksidasyon mikroflorasını bastırarak, fermantasyon mikroflorasının hakim olmasını sağlar. Bu, kokuşma ve çürümenin önüne geçer. Kokuşma sırasında oluşan hidrojen sülfit, amonyak ve merkaptanlar gibi kötü kokulu bileşikler yerine, antioksidan maddeler, vitaminler ve yararlı biyoaktif maddeler üretilir.
![]() Hidrojen sülfit ve kükürt, EM® içindeki fotosentetik bakteriler tarafından besin olarak kullanılır.
Hidrojen sülfit ve kükürt, EM® içindeki fotosentetik bakteriler tarafından besin olarak kullanılır.
![]() Amonyak, EM® içindeki nitrifiye edici bakteriler tarafından tüketilir.
Amonyak, EM® içindeki nitrifiye edici bakteriler tarafından tüketilir.
![]() Yağların bozunması sırasında oluşan kötü kokulu bileşikler, EM®’nin antioksidasyon etkisi sayesinde engellenir.
Yağların bozunması sırasında oluşan kötü kokulu bileşikler, EM®’nin antioksidasyon etkisi sayesinde engellenir.
Uygulamanın başında, suyun türbiditesinde (bulanıklık) bir artış görülebilir. Bu, EM® içindeki mantarların miselyum oluşturmasından kaynaklanır. Miselyum, mantarların toprak altındaki ipliğimsi yapılarıdır ve suda organik kirliliği absorblayarak zamanla çökelir. Miselyum, enzimler salgılayarak besinleri parçalar ve bu basit molekülleri difüzyon yoluyla absorbe eder.
![]() Miselyum, ekosistemlerde organik maddenin parçalanmasında ve bitkilerin su ve besin alımının artırılmasında önemli bir rol oynar.
Miselyum, ekosistemlerde organik maddenin parçalanmasında ve bitkilerin su ve besin alımının artırılmasında önemli bir rol oynar.
![]() Mikofiltrasyon (Mycofiltration), miselyumun biyolojik filtre olarak kullanılmasını ifade eder ve su arıtımında etkilidir.
Mikofiltrasyon (Mycofiltration), miselyumun biyolojik filtre olarak kullanılmasını ifade eder ve su arıtımında etkilidir.
![]() EM®, miselyum ve iyonlaşmayı bastırıcı etkisi sayesinde askıda katı madde (AKM) oranını azaltır.
EM®, miselyum ve iyonlaşmayı bastırıcı etkisi sayesinde askıda katı madde (AKM) oranını azaltır.
EM® ile KOİ ve BOİ’de Azalma
KOİ (Kimyasal Oksijen İhtiyacı) ve BOİ (Biyolojik Oksijen İhtiyacı), suyun kimyasal ve organik kirliliğini ölçen parametrelerdir. Mikroorganizmalar, organik maddeyi parçalayarak bu kirlilik yaratan maddeleri besin olarak kullanır. Ortam, mikroorganizmaların yaşaması için uygun olduğunda ve kirlilik (besin) varsa, mikroorganizmalar hızla çoğalır ve kirliliği yaratan maddeleri tüketerek KOİ ve BOİ değerlerini düşürür.
![]() Mikrobiyel aktivite devam ettiği sürece, arıtma işlemi de devam eder.
Mikrobiyel aktivite devam ettiği sürece, arıtma işlemi de devam eder.
![]() Mikroorganizmalar, besin maddelerini tüketene kadar yaşamlarını sürdürür. Besin tükendiğinde ise kendiliğinden yok olurlar.
Mikroorganizmalar, besin maddelerini tüketene kadar yaşamlarını sürdürür. Besin tükendiğinde ise kendiliğinden yok olurlar.
![]() Sürekli organik kirliliğin olduğu ekosistemlerde, organik maddenin tamamen tükenmesini beklemek gerçekçi değildir. Genellikle, mikroorganizmalar başka bir sınırlayıcı faktör nedeniyle ölürler. Bu nedenle, ekosisteme sürekli mikroorganizma ilavesi gerekir.
Sürekli organik kirliliğin olduğu ekosistemlerde, organik maddenin tamamen tükenmesini beklemek gerçekçi değildir. Genellikle, mikroorganizmalar başka bir sınırlayıcı faktör nedeniyle ölürler. Bu nedenle, ekosisteme sürekli mikroorganizma ilavesi gerekir.

Miselyumun Taramalı Elektron mikroskobunda çekilmiş fotoğrafı (x500)
EM® ile Nitratın Uzaklaştırılması
Nitratın uzaklaştırılması, göller, göletler, yapay göletler ve akarsulardaki organik madde kirliliğinin azaltılmasında önemli bir süreçtir. Organik madde, fotosentez yoluyla üretilir ve bitkiler tarafından enerji kaynağı olarak kullanılır. Bu enerji, yeryüzündeki yaşamın temelini oluşturur.
Fotosentez Reaksiyonu:
CO2(g)+H2O(s)→CH2O(k)+O2(g)ΔG=+475 kJ/molCO2(g)+H2O(s)→CH2O(k)+O2(g)ΔG=+475kJ/mol
Organik Maddenin Çürümesi (Aerobik Ortamda):
CH2O(k)+O2(g)→CO2(g)+H2O(s)ΔG=−475 kJ/molCH2O(k)+O2(g)→CO2(g)+H2O(s)ΔG=−475kJ/mol
EM®, içindeki aerobik mikroorganizmalar sayesinde aerobik ortamdaki çürümeyi hızlandırır. Ancak, anaerobik ortamdaki çürüme daha önemlidir.
Anaerobik Ortamda Organik Maddenin Çürümesi:
Denitrifikasyon:
5CH2O(k)+4NO3−(s)→CO2(g)+3H2O(s)+4HCO3−(s)+2N2ΔG=−448 kJ/mol5CH2O(k)+4NO3−(s)→CO2(g)+3H2O(s)+4HCO3−(s)+2N2ΔG=−448kJ/mol
Mangan Redüksiyonu:
CH2O(k)+3CO2(g)+H2O(s)+2MnO2→2Mn2++4HCO3−(s)ΔG=−349 kJ/molCH2O(k)+3CO2(g)+H2O(s)+2MnO2→2Mn2++4HCO3−(s)ΔG=−349kJ/mol
Demir Redüksiyonu:
CH2O(k)+7CO2(g)+4Fe(OH)3→4Fe2++8HCO3−(s)+3H2O(s)ΔG=−114 kJ/molCH2O(k)+7CO2(g)+4Fe(OH)3→4Fe2++8HCO3−(s)+3H2O(s)ΔG=−114kJ/mol
Sülfat Redüksiyonu:
2CH2O(k)+SO42−→H2S+2HCO3−(s)ΔG=−77 kJ/mol2CH2O(k)+SO42−→H2S+2HCO3−(s)ΔG=−77kJ/mol
Metan Ayrışması:
CH2O(k)→CH4+CO2(g)ΔG=−58 kJ/molCH2O(k)→CH4+CO2(g)ΔG=−58kJ/mol
Bu reaksiyonlar, su içindeki mangan, demir, sülfat ve nitrat konsantrasyonlarına bağlı olarak gerçekleşir. Denitrifikasyon, enerji açısından en tercih edilen reaksiyondur. Denitrifiye edici bakteriler, nitratı gaz halinde azota dönüştürür ve bu süreçte açığa çıkan enerji, hücre sentezinde kullanılır.
Doğadaki Azot Çevrimi ve EM®’nin Rolü
Denitrifikasyon, anaerobik koşullarda gerçekleşir. Ortamda oksijen olmadığı için gerekli oksijen, nitrat (NO₃⁻) ve nitritten (NO₂⁻) sağlanır. Denitrifikasyon sonucu gaz halinde azot (N₂) açığa çıkar. EM® ilavesi, bu süreci hızlandırarak nitrit ve nitrat miktarında azalma sağlar.
Denitrifikasyon Süreci:
NO3−→NO2−→NO→N2O→N2NO3−→NO2−→NO→N2O→N2
Denitrifikasyonda Rol Oynayan Mikroorganizmalar:
![]() Achromobacter, Aerobacter, Alkaligenes, Bacillus, Brevibacterium, Flavobacterium, Lactobacillus, Micrococcus, Proteus, Pseudomonas ve Spirillum. Bu mikroorganizmaların çoğu EM® içinde bulunur.
Achromobacter, Aerobacter, Alkaligenes, Bacillus, Brevibacterium, Flavobacterium, Lactobacillus, Micrococcus, Proteus, Pseudomonas ve Spirillum. Bu mikroorganizmaların çoğu EM® içinde bulunur.
EM®’nin Azot (N) Uzaklaştırılmasındaki Etkileri:
- EM®, içindeki mikroorganizmalar sayesinde amonifikasyon, nitrifikasyon ve denitrifikasyon süreçlerini hızlandırır.
- Fitoplanktonlar, EM® ile daha fazla besin alır ve büyür.
- EM® mikroorganizmaları ve diğer mikroorganizmalar, protein gibi besinleri kullanarak büyür. EM® varlığında, yerli mikroorganizmalar daha fazla besin alır ve hücre sentezi için gerekli enerji, denitrifikasyondan sağlanır.
- EM®, Askıda Katı Madde (AKM) miktarını azaltarak, partiküller üzerine adsorblanmış nitratın da azalmasını sağlar.
- Bokashi topları, nitratın adsorblanması ve biyolojik alımı için kullanılır.
Fosfatların Uzaklaştırılması:
- Fosfatların uzaklaştırılması, fiziksel, kimyasal ve biyolojik proseslerin birleşimiyle gerçekleşir.
- Düşük pH’lı sularda, demir (Fe) ve alüminyum (Al) fosfat mineralleri oluşur.
- Yüksek pH’lı sularda ise, kalsiyum fosfat oluşur.
- Partikül halindeki organik fosfor (P), Bokashi topları ve EM®’nin Askıda Katı Madde (AKM) azaltma etkisiyle çökeltilir veya mikroorganizmalar tarafından sentezlenerek uzaklaştırılır.
- Suda erimiş organik fosfor, biyolojik olarak inorganik fosfora parçalanır (mineralizasyon). EM®, bu süreci hızlandırır.
Fosfatların giderilmesi – Mekanizmalar
- EM® Mikroorganizmalarının Doğrudan Alımı: Hücre duvarı ve DNA yapısında kullanılır.
- Bokashi Topları Üzerine Adsorbsiyon: Fosfatlar, Bokashi toplarına adsorbe edilir.
- Fitoplanktonların Alımı: EM®, fitoplanktonların fosfat alımını artırır ve fitoplankton çeşitliliğini destekler.
- AKM Azaltma Etkisi: EM®, partiküller üzerindeki fosfatların çökeltilmesini sağlar.
- Kompleks Bileşik Oluşturma: EM®, demir (Fe) ve alüminyum (Al) ile kompleks bileşikler oluşturarak fosfatların çökelmesini hızlandırır.

BOKASHİ TOPLARI
“Bokashi” kelimesi Japonca’da fermente olmuş organik madde anlamına gelir. Bokashi Topu, Bentonit, Kil, EM® Seramik Tozu, Klorsuz Su, Şeker Kamışı Melası ve Etkin Mikroorganizma® (EM.1®) kullanılarak homojen bir şekilde karıştırılır. Bu karışımdan 150-300 gram ağırlığında toplar hazırlanarak, güneş görmeyen ılık bir ortamda beyazlanmalar oluşana kadar fermente edilir.
Deniz, göl, gölet, yapay gölet, biyolojik gölet, nehir, dere, çay, arıtma tesisleri ve sulak alanların dip çamuruna Etkin Mikroorganizma® (EM®) aşılamak amacıyla, metrekare başına 2-4 adet Bokashi Topu atılmalıdır.
Bokashi topları, devamlı kendi kendine EM® üreten bir depo gibi işlev görmektedir. İçeriğindeki kil tabakaları arasına yerleşen Etkin Mikroorganizmalar®, ortamda organik madde (kirlilik) olduğu sürece bir fabrika gibi üremeye devam edecektir.
EM PROSESİ
EM® içinde çok sayıda ve çeşitli mikroorganizma bulunmaktadır. Bu mikroorganizmalar, birbirleriyle rekabet etmeden, birbirlerine baskın çıkmadan ve birbirlerini destekleyerek bir arada yaşamaktadır. Bir mikroorganizmanın salgıladığı madde, diğeri için besin kaynağı oluşturur.
![]() Fermantasyon mikroorganizmaları, fotosentez bakterileri için mükemmel besinler üretir.
Fermantasyon mikroorganizmaları, fotosentez bakterileri için mükemmel besinler üretir.
![]() Fotosentez bakterileri tarafından salgılanan ATP, diğer mikroorganizmalar tarafından kullanılarak optimal mikroorganizma büyümesi sağlanır.
Fotosentez bakterileri tarafından salgılanan ATP, diğer mikroorganizmalar tarafından kullanılarak optimal mikroorganizma büyümesi sağlanır.
Mikroorganizmalar büyür ve ürer. Fotosentez bakterileri, serbest elektronları yakalayarak atıksu içinde bir antioksidasyon alanı oluşturur. Bu antioksidasyon alanı, iyonlaşma sürecini baskılar. Aynı zamanda, mikroorganizmalar tarafından antioksidan maddeler salgılanır. Bu maddeler sayesinde patojenlerin çoğalması engellenir. Bu süreçlerin sonucunda, atıksu arıtma tesisinde flokülasyon ve çökelmede artış gözlenir. Böylece atıksu temizlenmiş olur.

